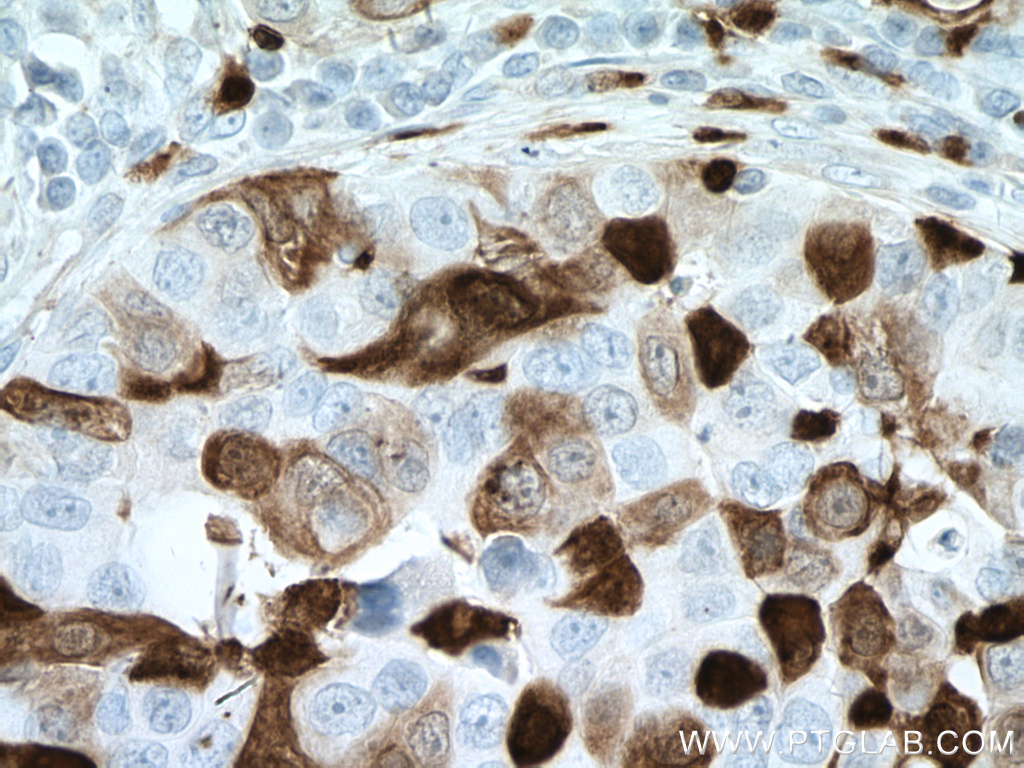

验证数据展示
经过测试的应用
| Positive IHC detected in | human tonsillitis tissue, human breast cancer tissue, human cervical cancer tissue, human liver cancer tissue Note: suggested antigen retrieval with TE buffer pH 9.0; (*) Alternatively, antigen retrieval may be performed with citrate buffer pH 6.0 |
| Positive IF-P detected in | human tonsillitis tissue |
推荐稀释比
| 应用 | 推荐稀释比 |
|---|---|
| Immunohistochemistry (IHC) | IHC : 1:250-1:1000 |
| Immunofluorescence (IF)-P | IF-P : 1:200-1:800 |
| It is recommended that this reagent should be titrated in each testing system to obtain optimal results. | |
| Sample-dependent, Check data in validation data gallery. | |
产品信息
66853-1-Ig targets S100A8 in WB, IHC, IF-P, ELISA applications and shows reactivity with human samples.
| 经测试应用 | IHC, IF-P, ELISA Application Description |
| 文献引用应用 | WB, IHC, IF |
| 经测试反应性 | human |
| 文献引用反应性 | human, mouse |
| 免疫原 |
CatNo: Ag8517 Product name: Recombinant human S100A8 protein Source: e coli.-derived, PET28a Tag: 6*His Domain: 1-93 aa of BC005928 Sequence: MLTELEKALNSIIDVYHKYSLIKGNFHAVYRDDLKKLLETECPQYIRKKGADVWFKELDINTDGAVNFQEFLILVIKMGVAAHKKSHEESHKE 种属同源性预测 |
| 宿主/亚型 | Mouse / IgG2a |
| 抗体类别 | Monoclonal |
| 产品类型 | Antibody |
| 全称 | S100 calcium binding protein A8 |
| 别名 | CFAG, Calprotectin L1L subunit, Calgranulin-A, Calgranulin A, CAGA |
| 计算分子量 | 93 aa, 11 kDa |
| GenBank蛋白编号 | BC005928 |
| 基因名称 | S100A8 |
| Gene ID (NCBI) | 6279 |
| RRID | AB_2882193 |
| 偶联类型 | Unconjugated |
| 形式 | Liquid |
| 纯化方式 | Protein A purification |
| UNIPROT ID | P05109 |
| 储存缓冲液 | PBS with 0.02% sodium azide and 50% glycerol, pH 7.3. |
| 储存条件 | Store at -20°C. Stable for one year after shipment. Aliquoting is unnecessary for -20oC storage. |
背景介绍
S100A8 is a member of the S100 family of proteins containing 2 EF-hand calcium-binding motifs. S100 proteins are localized in the cytoplasm and/or nucleus of a wide range of cells, and involved in the regulation of a number of cellular processes such as cell cycle progression and differentiation. S100 genes include at least 13 members which are located as a cluster on chromosome 1q21. This protein may function in the inhibition of casein kinase and as a cytokine.
实验方案
| Product Specific Protocols | |
|---|---|
| IF protocol for S100A8 antibody 66853-1-Ig | Download protocol |
| IHC protocol for S100A8 antibody 66853-1-Ig | Download protocol |
| Standard Protocols | |
|---|---|
| Click here to view our Standard Protocols |
发表文章
| Species | Application | Title |
|---|---|---|
Phytomedicine Geniposide via enema alleviates colitis by modulating intestinal flora and bile acid metabolites, inhibiting S100A8/S100A9/NF-κB, and promoting TGR5 inhibition of NLRP3 inflammasome | ||
J Cell Biol Giant worm-shaped ESCRT scaffolds surround actin-independent integrin clusters | ||
Biochim Biophys Acta Mol Cell Res IL-17 promotes melanoma through TRAF2 as a scaffold protein recruiting PIAS2 and ELAVL1 to induce EPHA5 | ||
Front Immunol Glomerular Expression of S100A8 in Lupus Nephritis: An Integrated Bioinformatics Analysis. | ||
J Transl Med Decoding the colorectal cancer ecosystem emphasizes the cooperative role of cancer cells, TAMs and CAFsin tumor progression | ||
Transl Oncol Single-cell RNA sequencing analysis revealed cellular and molecular immune profiles in lung squamous cell carcinoma |